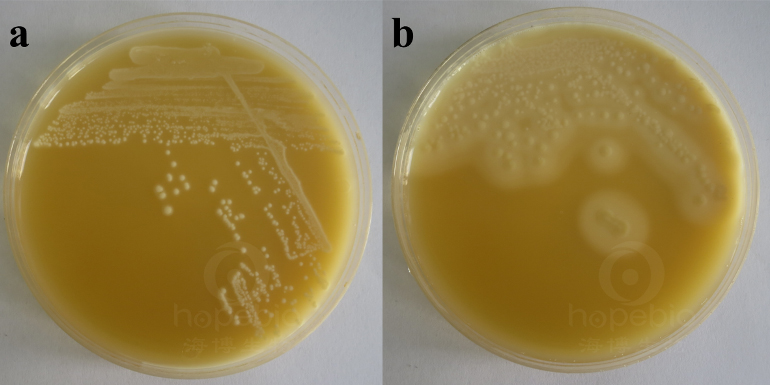
检测产气荚膜梭菌操作示意图,产气荚膜梭菌介绍

一、检验标准
《GB4789.13-2012 食品安全国家标准 食品微生物学检验 产气荚膜梭菌检验》
二、检验过程解析及注意事项
1.样品制备
无菌称取25g样品加入至含225mL0.1%蛋白胨水的均质袋中,均质1-2min,将制备好的样品液用含9mL0.1%蛋白胨水试管进行十倍系列稀释样液;
注意事项:产气荚膜梭菌为厌氧菌,暴露在空气中易死亡,因此从称样、制备样液、稀释、到倾注培养基进行培养整个过程要快速完成,如不能及时完成,可按标准要求置于2-5℃保存(数小时内)或加入缓冲-甘油氯化钠溶液置于-60℃冷冻保存。
2.分离计数
吸取制备好的样液加入至无菌空平皿中,加入约15mL的TSC培养基(冷却至50℃左右),混合均匀;待培养基凝固后,在上方覆盖约10mL的TSC培养基,凝固后置于厌氧环境内36±1℃培养20-24h;培养结束后,计数黑色菌落;
注意事项:
(1)注意倾注时的培养基温度和时间,培养基温度过高或操作时间过长都有可能导致产气荚膜梭菌死亡;
(2)覆盖培养基可防止菌落蔓延,并使产气荚膜梭菌菌落呈黑色(PS:部分产气荚膜梭菌若生长在培养基表面时会因产生的硫化氢逃逸,菌落呈现无色,导致漏检,覆盖培养基则可以留住硫化氢与培养基中的铁盐反应生成黑色的FeS,使菌落呈现黑色,因此必须要进行覆盖操作)。
3.分离纯化培养
用接种针(环)从TSC平板上挑取黑色菌落,接种至液体硫乙醇酸盐培养基中,36±1℃培养18-24h;
注意事项:液体硫乙醇酸盐培养基自身可形成厌氧环境,无需覆盖石蜡或置于厌氧环境培养(不可振荡培养,液体流动会破坏下层的厌氧环境),接种前注意氧化层的高度(可在临用前水浴加热驱氧),接种时需至氧化层以下,产气荚膜梭菌可在氧化层以下呈颗粒或条状生长,有时可见产气,在培养基表面生成大量气泡。详情请参考: 液体硫乙醇酸盐培养基原理及注意事项
4.产气荚膜梭菌鉴定
鉴定试验:纯化后的可疑菌做革兰氏染色,并做暴烈发酵试验、乳糖-明胶试验和动力-硝酸盐试验。典型的产气荚膜梭菌为革兰氏阳性粗短的杆菌,有时可见芽孢,暴烈发酵试验阳性,乳糖阳性,明胶阳性,硝酸盐还原阳性,动力阴性。
暴烈发酵试验: 图1中a,b为产气荚膜梭菌暴烈发酵试验结果,c为阴性对照,d为空白管。接种时使用移液管或移液枪吸取1mL的FTG培养物伸入至含铁牛奶试管中培养基液面下方,缓慢加入菌液,更易观察到明显的暴烈发酵现象。

图1暴烈发酵试验现象
乳糖-明胶试验: 产气荚膜梭菌可发酵乳糖,使培养基变黄,并液化明胶,使培养基呈液态不凝固。
注意事项:
(1)产气荚膜梭菌为厌氧菌,此生化反应需大量接种更易看到试验结果,实际操作时若用接种针挑取FTG培养物直接接种需氧培养,可能会遇到由于接种量不足和需氧培养导致菌不生长的情况,可以采用吸取0.1mL的FTG培养物或挑取平板上的大量菌苔接种方式后厌氧培养,更易观察到试验结果;
(2)明胶的凝固点在30℃左右,因此在36℃培养结束时,明胶是呈液态的,所以必须要放入低温环境使培养基冷却,再观察培养基是否呈液态状;
(3)不同细菌液化明胶能力有差别,增菌接种量可以更快观察到明胶液化现象,因此遇到明胶不液化问题时,可以尝试增大接种量或延长培养时间再观察试验结果。

图2产气荚膜梭菌的乳糖-明胶试验现象
动力-硝酸盐试验: 产气荚膜梭菌无动力,在培养基中沿穿刺线生长;硝酸盐还原阳性,加入硝酸盐还原试剂后变红。
注意事项:
(1)同乳糖-明胶试验,用接种针挑取FTG培养物穿刺接种需氧培养可能观察不到菌生长,可采用接种针挑取菌苔穿刺接种方式进行培养,再观察结果;
(2)观察硝酸盐还原试验时,若滴加试剂后不变红,原因有2:①由于细菌不还原硝酸盐(-),②细菌将硝酸盐还原为亚硝酸盐,又继续将亚硝酸盐还原为氮气、氨、氮氧化物等(+);因此当出现滴加试剂不变红时,需要补加锌粉或锌粒,检测培养基中的硝酸盐是否存在。锌可以将硝酸盐还原为亚硝酸盐,加入锌之后若出现缓慢变红现象,说明培养基中有硝酸盐存在,未被细菌还原,可判为硝酸盐还原阴性;加入锌之后若没有颜色变化,说明培养基中的硝酸盐已全部被细菌还原,也可判为硝酸盐还原阳性。

图3产气荚膜所的动力-硝酸盐试验现象
三、试验结果说明及其他鉴定试验
检验结果在TSC上呈黑色菌落,革兰氏染色为阳性短杆菌,生化鉴定符合暴烈发酵(+),乳糖(+),明胶(+),动力(-),硝酸盐还原(+),即可判为产气荚膜梭菌。
在《GB8538-2016 食品安全国家标准 饮用天然矿泉水检验方法》标准中,对产气荚膜梭菌鉴定有一项卵黄试验,产气荚膜梭菌会产生卵磷脂酶,分解卵黄中的卵磷脂,在菌落周围形成沉淀环,该特征反应也可做为产气荚膜梭菌的鉴定补充试验。
a:金葡菌ATCC6538乳白色菌落无浑浊带b:产气荚膜梭菌ATCC13124乳白至淡黄色菌落有较大浑浊带